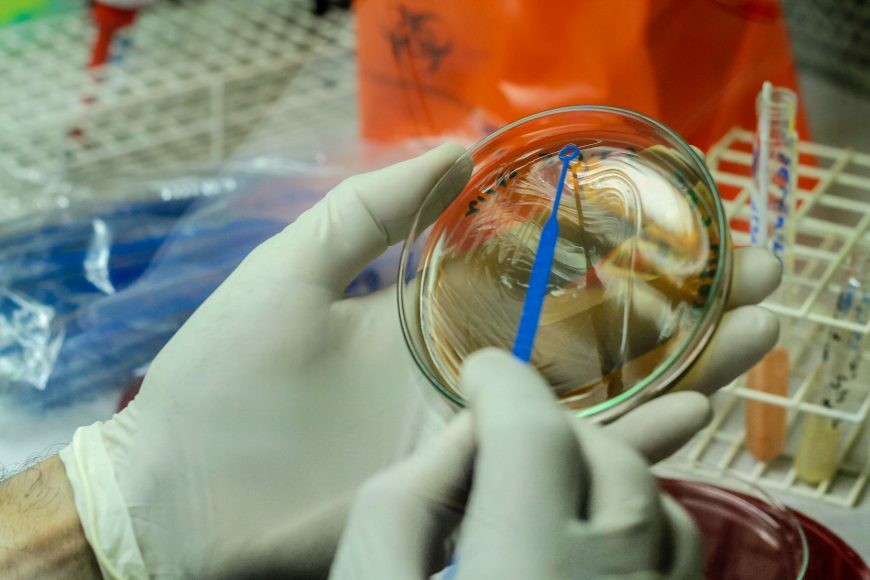

Casos foram identificados em 16 cidades do estado, conforme boletim de quarta (31) da Sesa. Estado tem 170 casos suspeitos em investigação. Paraná confirma mais 38 casos de varíola dos macacos Daiane Mendonça/ Governo de Rondônia O Paraná confirmou 38 novos casos de varíola dos macacos conforme divulgado pela Secretaria de Estado da Saúde (Sesa) na quarta-feira (31). Com o aumento, o estado chegou a 143 diagnósticos positivos da doença. Os casos foram identificados em 16 municípios paranaenses. Ainda conforme a Sesa, os novos registros foram feitos nos seguintes municípios: Curitiba (26); Londrina (4); Cascavel (3); Campo Largo (1); Corbélia (1); Foz do Iguaçu (1); Mangueirinha (1); Paranaguá (1). Curitiba é a cidade com o maior número de casos: 110 no total. Secretaria de Saúde divulga orientações sobre varíola dos macacos Dos casos confirmados, 135 foram de homens e 8 pacientes mulheres. A Sesa analisa mais 170 casos considerados como suspeitos. Saiba mais sobre a doença A varíola dos macacos é provocada pelo vírus Monkeypox. A transmissão entre humanos ocorre, principalmente, por meio de contato com lesões de pele de pessoas infectadas. A infecção causa erupções que, geralmente, se desenvolvem pelo rosto e depois se espalham para outras partes do corpo. Os principais sintomas envolvem febre, dor de cabeça, dores musculares, dores nas costas, linfadenopatia, calafrios e fadiga. VÍDEOS: Mais assistidos do g1 PR Veja mais notícias em g1 Paraná.

Leia mais: https://g1.globo.com/pr/parana/noticia/2022/09/01/parana-confirma-mais-38-casos-de-variola-dos-macacos.ghtml








